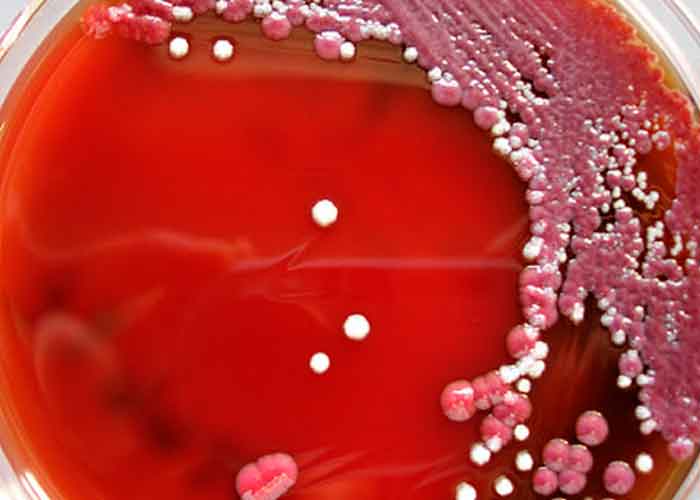
citrobacter italia

Tras las denuncias de algunos padres, una investigación desveló que fue una bacteria, la Citrobacter, que se encontraba en uno de los grifos de agua para limpiar biberones en la unidad de cuidados Intensivos del Hospital de la Mujer y el Niño de Verona (norte de Italia), la causante de la muerte de cuatro bebes y daños, algunos muy graves, en otros 96, entre 2018 y este año.
Esta es la conclusión a la que llega el informe de una de las dos comisiones designadas por la región de Veneto, tras las denuncias de los padres de los niños que publicó hoy el diario local "Corriere del Veneto."
Según las conclusiones de esta investigación, que será entregada a la fiscalía, el citrobacter habría colonizado el grifo quizás por no respetar las medidas de higiene, aunque otra hipótesis es haber utilizado agua del grifo en lugar de agua esterilizada.
Lea además: Las dos Coreas, en estado de alerta máxima por un tifón Maysak
Los primeros controles por parte de dirección del hospital habían comenzado en enero y luego se interrumpieron debido a la emergencia del coronavirus.
"La región y el hospital se encuentran a disposición de las autoridades investigadoras en todos los aspectos", explicó el presidente de la Región de Veneto, Luca Zaia.
Los padres de los niños han denunciado que el hospital quiso encubrir la situación y que se les explicó que era algo que podía pasar.
Sin embargo una de las madres, al hablar con otras afectadas, descubrió que estaba siendo algo común en el hospital.
Francesca Frezza, madre de una de las bebes, fue la primera en denunciar públicamente el incidente a fines de 2019, pidiendo la renuncia de los jefes del hospital.
"Estoy aquí porque la comisión responsable confirmó todo lo que siempre había pensado: mi hija murió por deficiencias higiénico-sanitarias", comentó la mujer, que junto con los familiares de los otros bebes fallecidos se manifestó ante el hospital pidiendo responsabilidades.
Esta bacteria que provoca infecciones, sobre todo urinarias, también puede atacar al cerebro y dos de los niños murieron porque la invasión de la bacteria atacó totalmente este órgano.